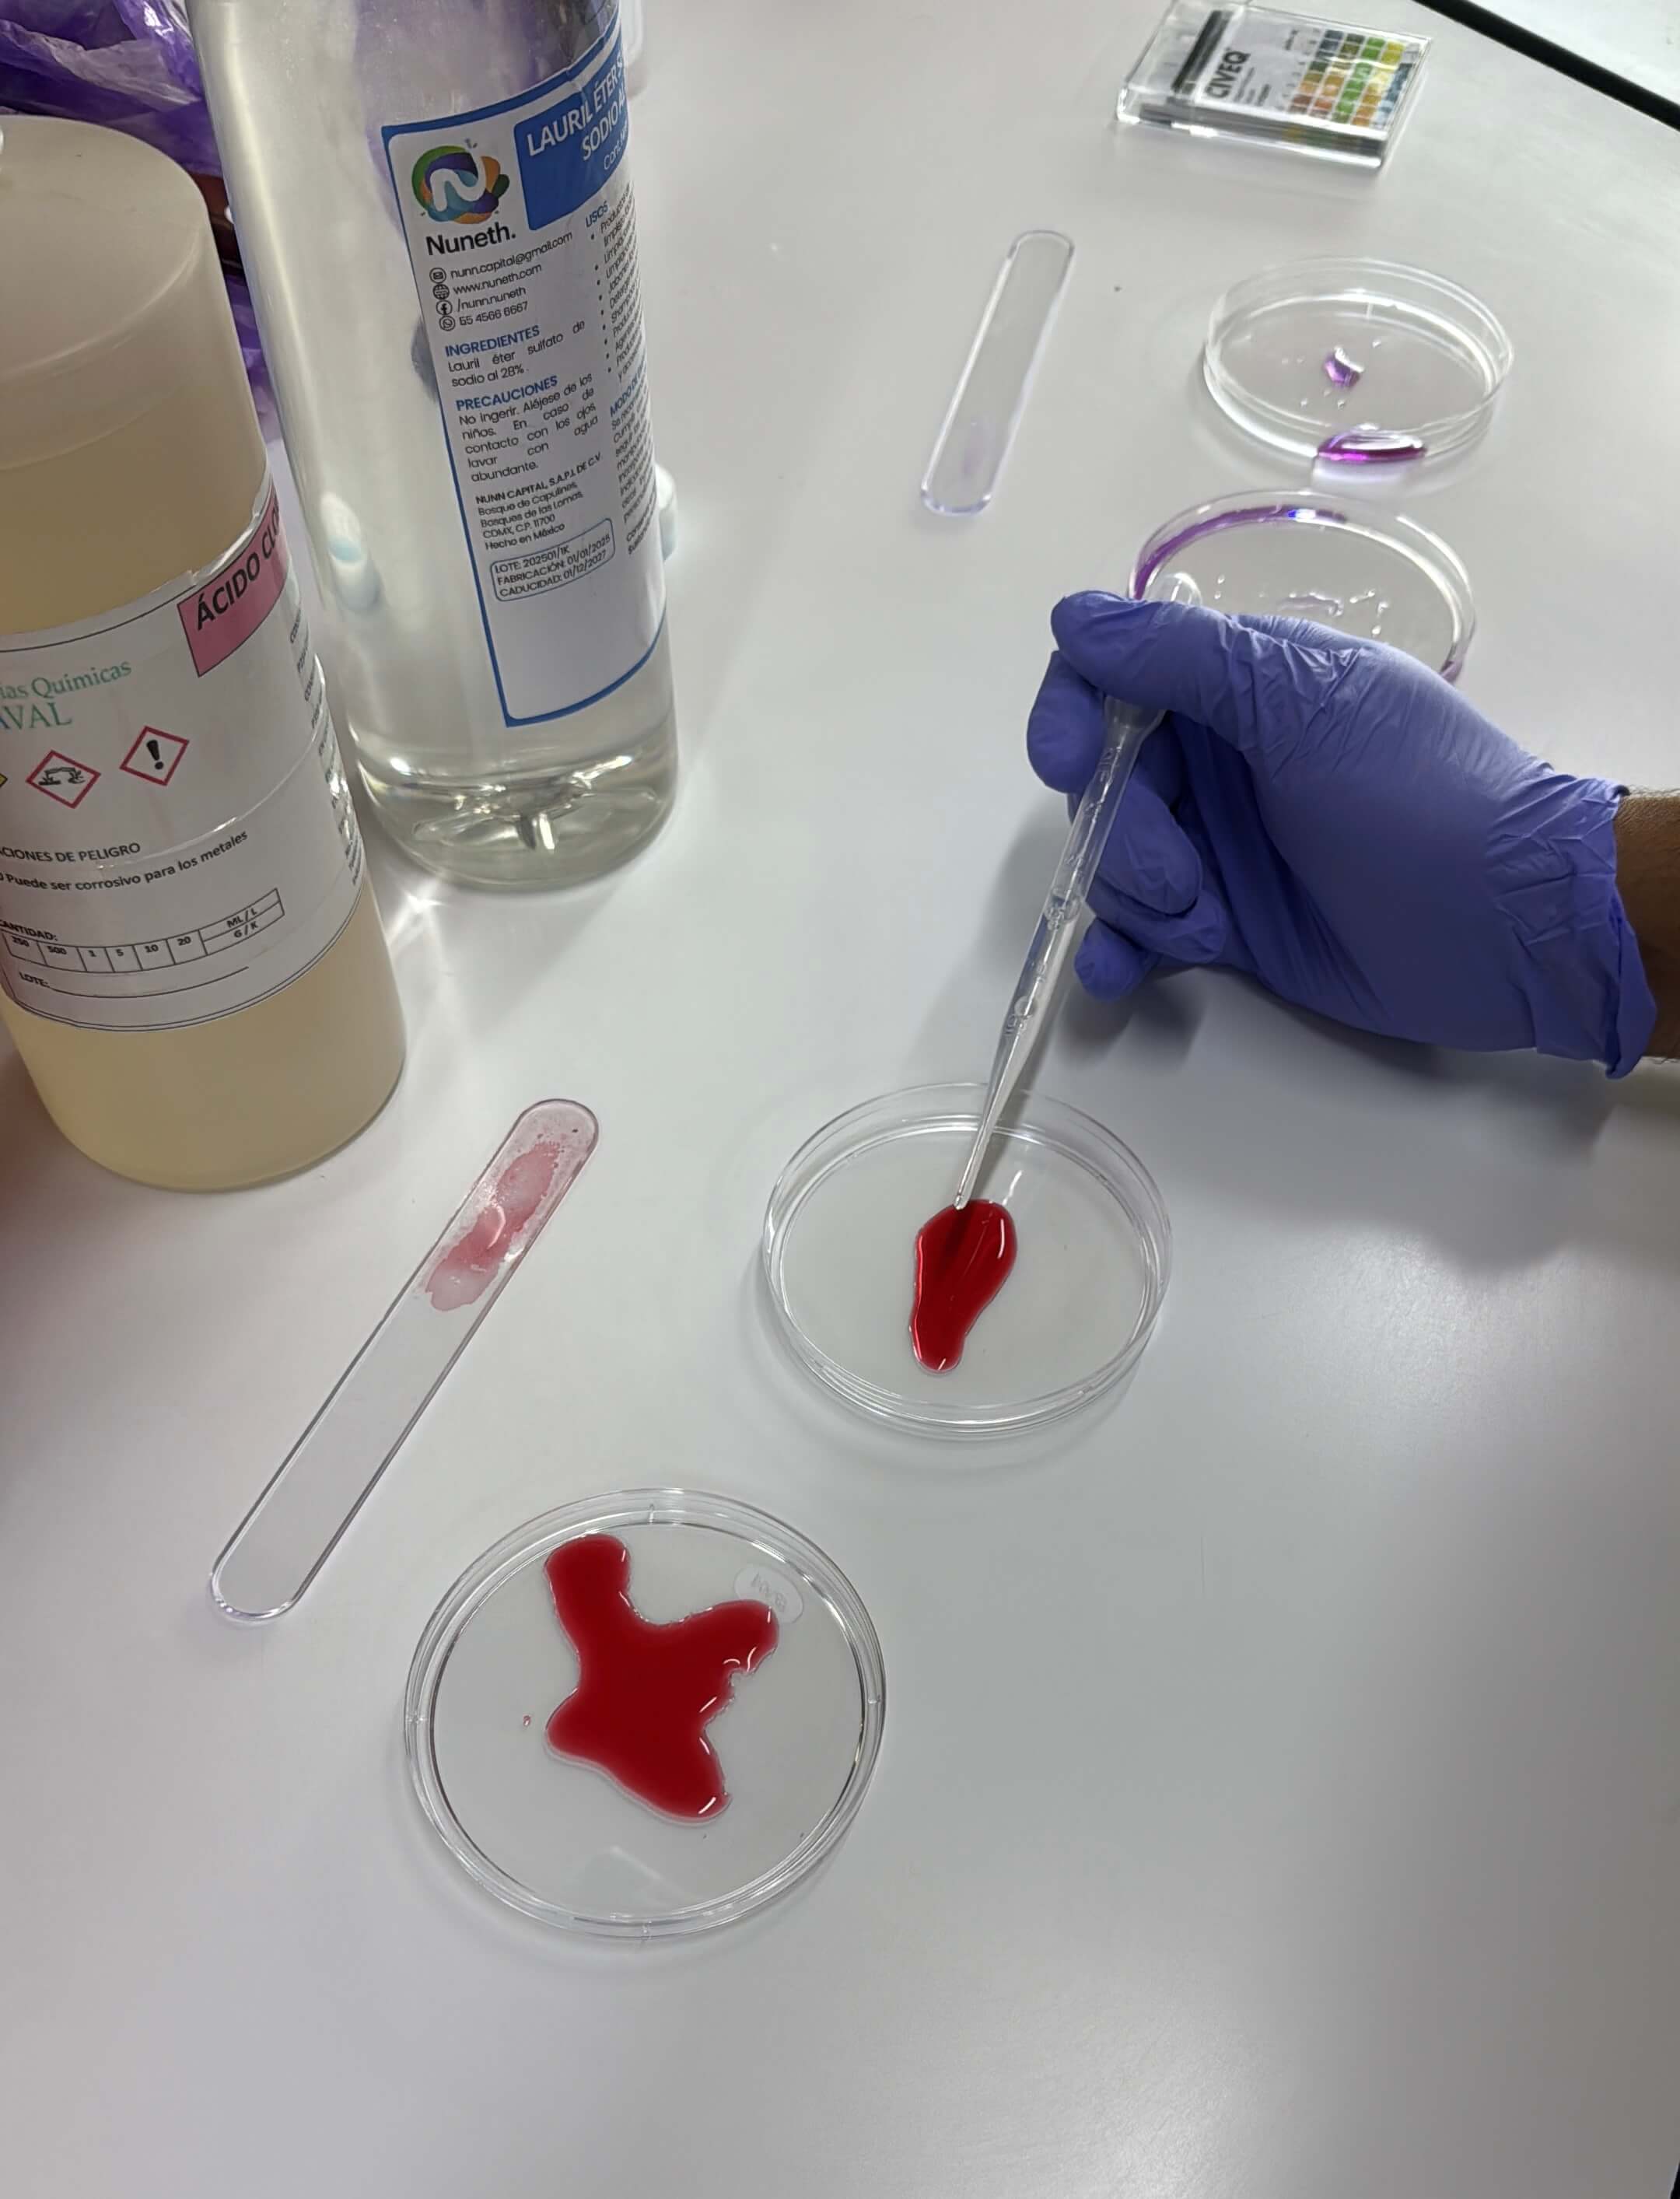

4. BioChromes¶

"I found I could say things with color and shapes that I couldn't say any other way, things I had no words for." -Georgia O'Keeffe
Color is all around us and always has been. As Cecilia said in class, color gives life, hence its importance. I hadn't really stopped to reflect on the importance of experimenting with biochromes, which are a response to the damage caused by highly toxic chemicals used in the textile industry. As written by Isobel Leonard, biochromes are color matter produced by a living organism. They are based on the principles of being local, biobased, and compostable, as well as having zero waste.
Inspo⋆¶
Following this philosophy, the Wild Pigment Project, founded by artist Tilke Elkins, is a project focused on the ethical foraging and creation of natural pigments. The project is guided by the concept of 'Reciprocal Foraging,' a philosophy that views the act of collecting as an energy exchange where respect and giving are essential. Its three pillars are:
Reciprocity with the Earth 𓆝 𓆟 𓆞 : The main philosophy is the belief that the Earth is alive. The project requires taking only what is abundant and necessary, and offering gifts back to the land in exchange (time, care, respect, and gratitude).
Social Justice and Reparation ⚠︎ : Operating on Chifin Kalapuya lands (Oregon), the project is dedicated to fostering conversations about land histories. A crucial component is racial and territorial justice, donating a portion of sales (such as 22% of the Qa’Pai pigment) to organizations that support Indigenous and Black communities.
On their website, you can view their visual gallery of natural pigments, where they provide the pigment's name, meaning, material, use, foraging location, origin, processing method, and action of reciprocity.
Tools, Materials & Ingredients 𖤥𓇢𓆸¶
- Metal Bowls
- Grill
- Scale
- Measuring cup
- Pipettes
- Mixing sponns
- Petri Dish
- Ph strips
- Mortar and Pestle
- Scissors
- Wool
- Cotton duck
- Baking soda
- Distilled water
- Alum
- Hydrocholoric acid
- Sodium Laureth sulfate
- Beetroot
- Dried Annatto
Process and workflow ꔛ¶

Puebla´s node working station.
First, we cut the wool and blanket (or fabric) into 10x10 cm squares. Since everyone in the group (or node) was making their pigments at the same time, we cut all of them together. We separated the fabrics by type, weighed them, and then placed them in a metal bowl with distilled water and boiled them with baking soda. We let them boil for an hour and then set them aside. This process it´s neccesary for washing the fabric. After that time, we mixed the types of fabric, added alum, and then let them boil for an hour as well, this is called mordanting, so that the pigment adheres to the fabric and lasts longer.
Ratio1:
The amount of baking soda needed is 2% of the total weight of your fabric, while the alum is 10%.
By Samantha Sánchez, 2025
While this was happening, I cut a medium-sized beetroot into cubes and boiled it, also in a bowl with distilled water, until the water covered the beetroot. We left this on the heat for approximately an hour and a half; we knew it was time to turn off the heat when the beetroot cubes started to lose their color.


For the pigment, I experimented with dried annatto. I ground this in a mortar and pestle until it became a powder.
Tip: It takes a long time to pulverize because it is a hard seed, so if you're doing it by hand, be patient.
I then boiled the 20g of annatto powder in a bowl with distilled water until the seeds lost their color. Afterward, I strained the dye through a piece of fabric to remove the seeds.

For the modifiers, I used hydrochloric acid and Sodium Laureth Sulfate (SLES). I divided a few drops of the die into three Petri dishes: one for the acid, one for the SLES, and one without any modifier, with the intention of measuring the pH levels of each one.
For this test you just need one drop of a modifier, measure it with a pippette.
Meassuring pH ✎¶

Beetroot dye with modifiers
- Swatch on the left: Beetroot pH with hydrochloric acid, acidic.
- Swatch on the right: Beetroot pH with Sodium Laureth Sulfate, neutral.

Dried annatto dye with modifiers
- Swatch on the left: Dried annatto pH with hydrochloric acid, acidic.
- Swatch on the right: Dried annatto pH with Sodium Laureth Sulfate, neutral.
Then, i began by submerging the wool and cotton duck pieces in the dye baths, dividing the dye into three parts. I added hydrochloric acid to one container, SLES (Sodium Laureth Sulfate) to another, and left the last one neutral.
Ratio 2:
Amount of modifier to add: 10% of the total dye volume (in ml).
I let the fabric soak for a couple of days... which was bit of a mistake :(
But I'll explain that later on.
About the ingredients ❁¶

The vibrant and earthy beetroot, also known as the garden beet, is the cultivated root of the Beta vulgaris species. Its wild ancestor, the sea beet, originated along the coasts of the Mediterranean and the Middle East. The beetroot, known in Mexico as betabel, is not native to the Americas. Its introduction to Mexico occurred during the Spanish colonial period as part of the transatlantic exchange of crops. The vegetable became established and adapted well to Mexico's diverse climates. Today, betabel is a widely grown and harvested crop year-round, with key production areas in states like Puebla and Jalisco, serving both culinary markets and the food industry (as a source of natural colorant and sugar).
Blackbird and Violet, "Beetroot botanicals"

Annatto (or achiote, derived from the Nahuatl word achiotl meaning "red dye") is a plant native to tropical America and a foundational element of Mexican culture. Unlike the beetroot, the annatto plant (Bixa orellana) was cultivated and utilized extensively by pre-Columbian civilizations, particularly the Maya and Aztecs. Annatto is indigenous to the neotropics, with significant historical cultivation in Mexico, Central America, and South America. Today, annatto is indispensable to Mexican cuisine, especially in the Yucatán Peninsula , where it is the base for dishes like Cochinita Pibil. As well as it´s essential for tacos al pastor flavor and color. Annatto continues to be used by artisans and Indigenous communities in Central and South America. They value it for its cultural heritage and the warm color range it produces (from yellowish-orange to reddish-pink).
Descourtilz, Michel-Étienne. "Flore pittoresque et médicale des Antilles, vol. 1", 1821
Results ⟡¶
Beetroot

On the left an image of a wool sample with no modifiers . This was the mistake i was talking about the wool fabric got moldy due to humidity.
On the right, an image of a cotton duck sample with no modifiers . Dye didn´t adhere much to the fabric.

On the left an image of a wool sample with hydrochloric acid . The dye is more burgundry.
On the right, an image of a cotton duck sample with hydrochloric acid . Here the dye didn´t adhere much to the fabric.

On the left an image of a wool sample with Sodium Laureth Sulfate . The mold affected the color result.
On the right, an image of a cotton duck sample with Sodium Laureth Sulfate . Here the dye shows up a litte bit more, it´s a brown-ish color.
Annatto

On the left an image of a wool sample with no modifiers . The dye on the wool looks like a ochre yellow.
On the right, an image of a cotton duck sample with no modifiers . Dye adhered better to the fabric.

On the left an image of a wool sample with hydrochloric acid . The dye it´s more orange.
On the right, an image of a cotton duck sample with hydrochloric acid . Here the dye looks orange as well.

On the left an image of a wool sample with Sodium Laureth Sulfate .
On the right, an image of a cotton duck sample with Sodium Laureth Sulfate .
2nd try ✶¶
Since the beetroot dye on wool with both modifiers grew mold and I couldn't appreciate the colors on this fabric, I decided to repeat the dye bath. These were the results:

On the left an image of a wool sample with Sodium Laureth Sulfate .
On the right, an image of a wool sample with hydrochloric acid .
Recycling the dye into pigment ˚⋆𖦹¶
With the leftover beetroot dye that had hydrochloric acid (it was my favorite), I wanted to follow the systemic, zero-waste approach that Cecilia presented to us in class and transform it into something more. In this case, I wanted to do screen printing, so I followed the corresponding process to obtain this type of printing ink.
Illustration by Cecilia Raspanti, Biochromes Color Archive
Ingredients & Recipe¶
ingredients
- 60 ml liquid dye
- alum (follow mordant ratio)
- 4 gr xantan gum
- 125 ml water

I mixed the mordant with the dye, following the ratio (10% of the total weight). Afterwards, in a food processor, I mixed the 125 ml of water with 4 grams of xanthan gum. I did this to achieve the desired viscosity and to ensure the gum mixed correctly without clumps. Once mixed, I combined one tablespoon of this mixture with one tablespoon of the dye. I did this to ensure the color intensity was maintained while also achieving the desired density.
Upcycling a T-shirt ◡̎¶

The design for screen printing on the shirt was inspired by a very popular cat meme. I find it both hilarious and adorable because of how silly it looks. I wanted to use a white shirt (100% cotton) that I no longer used and was thinking of donating, to give it new life and make me want to wear it.
I created the 3negative drawing using vectors, with the help of Adobe Illustrator.
To prepare my red cat design for the plotter, I used the Inkscape software. First, I verified the Document Properties in Inkscape, making sure the workspace area was configured to be 150 mm wide and 200 mm high.
Next, I opened the plotting and configuration tool by going to Extensions → Export → Plot... within Inkscape.
In the Connection Setup tab, I configured the serial communication: I set the Serial Port to COM4 and the Baud rate to 9600. I kept the Command Language as HPGL.
In the Plotter Settings tab, I confirmed the 1016 dpi precision for both X and Y resolutions. I also indicated the Pen Number (1), although I left the initial Force and Speed at 0 to adjust them directly on the machine.
Finally, I briefly checked the option to generate GCode in the Inkscape extensions, but my primary setup was based on HPGL plotting.


- Cut design in red adhesive vinyl

- I removed the excess vinyl to leave the design intended for the shirt, put it on transfer paper, and pressed it onto my frame.
PREPARING THE T-SHIRT:

I used the same ratio of baking soda and mordant (alum) and the same process I mentioned at the beginning. The amounts varied based on the weight of my shirt, which was 100g, so I adjusted the measurements accordingly.

I placed the frame over my shirt, added the paint, and spread it across the screen with a spatula.
Results¶

